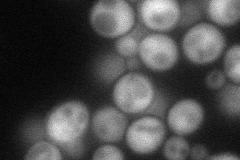
YGL254W
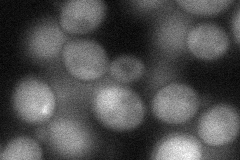
YGL254W
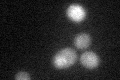
YGL254W

View description
Transcription factor involved in sulfite metabolism, sole identified regulatory target is SSU1, overexpression suppresses sulfite-sensitivity of many unrelated mutants due to hyperactivation of SSU1, contains five zinc fingers
Localization:
Intensity:
Fold change:
Significance:
-
C’ GFP library in SD

below threshold16.57 -
N' NOP1pr-GFP in SD
cytosol72.8149 -
N' TEF2pr-mCherry in SD

cytosol379.984 -
N' NATIVEpr-GFP in SD

cytosol22.2604 -
N' TEF2pr-VC and Cyto-VN in SD
cytosol47.7324 -
C’ GFP library in SD+DTT
cytosol17.961.08No -
C’ GFP library in SD+H2O2

cytosol16.681No -
C’ GFP library in Starvation Media

cytosol16.180.97No -
C’ GFP library on the background of Pup2-DaMP

below threshold -
C’ GFP library on the background of CCT mutant

below threshold17.39711.04942No
